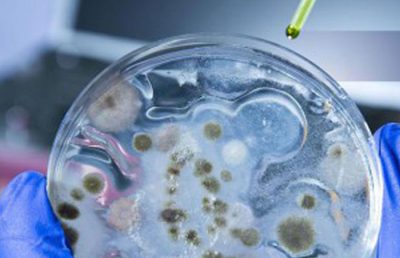

Royan Institute
Infertility treatment & Cell Therapy Center
Royan Institute
Group : Hi Tech
Company work : Infertility treatment & Cell Therapy Center
Services : Human In Vitro Fertilization, Pets Reproductive Cloning, Germ Cell and Human embryo freezing, Pre-implantation genetic diagnosis,Tissue engineering, Production of recombinant proteins, Production and isolation of embryonic stem cells of adults and umbilical cord, Transgenic goats production, Production of animal embryos, Transplant medicine by using stem cell therapy, Private and public banks of cord blood stem cells, Bank of embroynic stem cells and induced pluripotent( Royan)
MIM Daroo Pharmaceutical Company was established in 2009 by the goal of creating a curative drug for migraine disease. After many years of rigorous research and large clinical trials at the only migraine clinic in the Middle East (Aramesh Multidisciplinary Pain Clinic of Tehran), MIM Daroo Pharmaceutical Company introduced the first curative medicine For migraine headaches in 2009. The original newly developed drug was in the form of inhalation and needed special processes to be used only at the clinics. The R&D team of MIM Daroo was then encouraged to develop a new version of migraine curative medicine. In 2016, MigraineCut , the first nasal spray to cure migraine passed all the requirements and was registered in Food and Drug Administration (FDA) of Iran and received its mass industrial production license. MIM Daroo company now working in herbal and Nature based treatments for common annoying diseases such as Allergy, Eczema, Sinusitis and … and the research and developments team have achieved very promising results in treating these diseases.